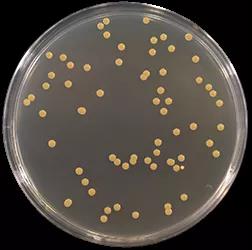
圖片
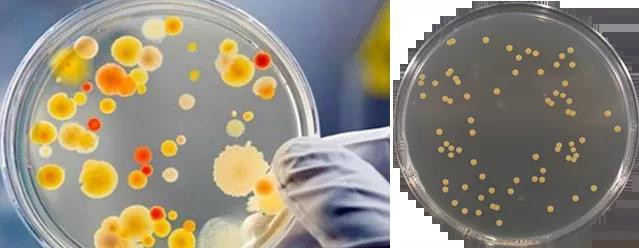
圖片
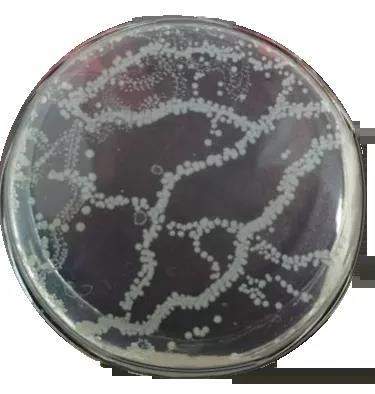
圖片

一、菌落總數定義和衛生學意義
•菌落總數定義:指在一定條件下(如需氧情況、營養條件、pH、培養溫度和時間等)每克(每毫升)檢樣所生長出來的菌落數,
•衛生學意義:菌落總數測定是用來判定食品被細菌污染的程度及衛生質量,它反映食品在生產過程中是否符合衛生要求,以便對被檢樣品做出適當的衛生學評價。菌落總數的多少在一定程度上標志著食品衛生質量的優劣。
二、GB4789.2-2016菌落總數測定(平板法)
1、菌落總數檢驗流程圖


2、結果計數
•可用肉眼觀察,必要時用放大鏡或菌落計數器,記錄稀釋倍數和相應的菌落數量。菌落計數以菌落形成單位(colony-formingunits,CFU)表示。
•選取菌落數在30CFU~300CFU之間、無蔓延菌落生長的平板計數菌落總數。低于30CFU的平板記錄具體菌落數,大于300CFU的可記錄為多不可計。每個稀釋度的菌落數應采用兩個平板的平均數。
•其中一個平板有較大片狀菌落生長時,則不宜采用,而應以無片狀菌落生長的平板作為該稀釋度的菌落數;若片狀菌落不到平板的一半,而其余一半中菌落分布又很均勻,即可計算半個平板后乘以2,代表一個平板菌落數。

•當平板上出現菌落間無明顯界線的鏈狀生長勢,則將每條單鏈作為一個菌落計數。
3、結果計算
•若只有一個稀釋度平板上的菌落數在30~300CFU之間,計算兩個平板菌落數的平均值,再將平均值乘以相應稀釋倍數,作為每g(mL)樣品中菌落總數結果。
•若所有稀釋度的平板上菌落數均大于300CFU,則對稀釋度最高的平板進行計數,其他平板可記錄為多不可計,結果按平均菌落數乘以最高稀釋倍數計算。
•若所有稀釋度的平板菌落數均小于30CFU,則應按稀釋度最低的平均菌落數乘以稀釋倍數計算。
•若所有稀釋度(包括液體樣品原液)平板均無菌落生長,則以小于1乘以最低稀釋倍數計算。
•若所有稀釋度的平板菌落數均不在30CFU~300CFU之間,其中一部分小于30CFU或大于300CFU時,則以最接近30CFU或300CFU的平均菌落數乘以稀釋倍數計算。
•若有兩個連續稀釋度的平板菌落數在適宜計數范圍內時,按式(1)計算:

4、結果報告
•菌落數小于100CFU時,按“四舍五入”原則修約,以整數報告。
•菌落數大于或等于100CFU時,第3位數字采用“四舍五入”原則修約后,取前2位數字,后面用0代替位數;也可用10的指數形式來表示,按“四舍五入”原則修約后,采用兩位有效數字。
•若所有平板上為蔓延菌落而無法計數,則報告菌落蔓延。
•若空白對照上有菌落生長,則此次檢測結果無效。
•稱重取樣以CFU/g為單位報告,體積取樣以•CFU/mL為單位報告。
•注:菌落總數結果計算與報告方式實例見以下表格








當前所在頁面:















